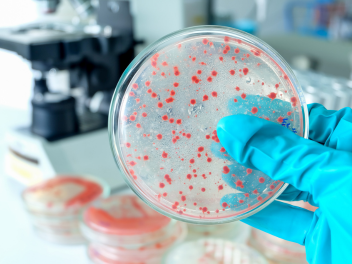
related-services-microbiology

Unsere Prüf- und Beratungskompetenz
Umfassende Audit-Dienstleistungen
Prüfen Sie Ihre Lieferkette, Produktionsstandorte und Vertriebsprozesse durch Audits vor Ort oder aus der Ferne. Gewährleisten Sie die Einhaltung von GMP-Standards (ISO 22716) sowie regulatorischer Vorgaben, wie z. B. FDA, EU-Verordnung Nr. 1223/2009, ANVISA RDC 48-2013 usw.
Strategische Beratungsleistungen
Decken Sie durch umfangreiche Analysen Compliance-Lücken auf, die Sie anschließend durch Maßnahmen (CAPAs) korrigieren. Optimieren Sie Ihre Qualitätssysteme, validieren Sie Prozesse und gewährleisten Sie konforme regulatorische Dateneinreichung – mit fachkundiger Beratung, die individuell auf Ihre Anforderungen zugeschnitten ist.
Schulungsprogramme zur Regulatorik
Nutzen Sie individuell zugeschnittene Schulungen zu technischen und regulatorischen Themen. Lassen Sie Ihrem Team das nötige Wissen zukommen, um komplexe globale Anforderungen sicher und souverän zu meistern.
Globale Compliance-Expertise
Nutzen Sie das weltweite Netzwerk von Eurofins-BeraterInnen, um sicherzustellen, dass Ihre Produkte marktgerechten Regularien entsprechen – darunter DSGVO sowie der EU-Verordnung Nr. 831/2019.
Problem, sich im internationalen Regelwerk zurechtzufinden?
Eurofins Cosmetics & Personal Care (C&PC) bietet Servicedienstleistungen in den Bereichen Audit, Beratung und Schulung. Wir unterstützen Sie bei der Erfüllung von regulatorischen Anforderungen, Optimierung Ihrer Qualitätssysteme und der effizienten Gestaltung Ihrer Abläufe. Unsere maßgeschneiderten Lösungen sorgen dafür, dass Ihre Produkte internationalen Standards entsprechen – und dabei zuverlässig und wirtschaftlich bleiben.

Innovationen sicher umsetzen – mit Eurofins an Ihrer Seite
Profitieren Sie von Eurofins Cosmetics & Personal Care (C&PC) an Ihrer Seite durch führende Branchenexpertise in Regulatorik, Prozessoptimierung und Schulung Ihrer MitarbeiterInnen.
-
Globale regulatorische Unterstützung:
Stellen Sie die Einhaltung internationaler Standards in den jeweiligen Märkten sicher – mit unserem weltweiten Netzwerk an ExpertInnen. -
Individuelle Lösungen:
Erfahren Sie maßgeschneiderte Audits, Beratungen und Trainingsprogramme, die exakt auf Ihre individuellen Anforderungen abgestimmt sind. -
Erprobte Expertise:
Profitieren Sie von jahrzehntelanger Erfahrung in GMP-Audits, CAPA-Umsetzung und der Optimierung von Qualitätssystemen. -
Zeitnaher Marktzugang:
Optimieren Sie Ihre Prozesse für eine termingerechte Produkteinführung – bei gleichbleibend hohen Standards für Sicherheit und Qualität.

Expertise für Kosmetikmarken:
Audits, Beratung und gezielte Trainings aus einer Hand
Eurofins Cosmetics & Personal Care (C&PC) unterstützt Sie fachkundig bei Ihren Audits zur Bewertung von Lieferketten und Produktionsstandorten. Wir beraten Sie zur Optimierung von Qualitätssystemen und Gewährleistung der regulatorischen Konformität und bieten Ihnen maßgeschneiderte Schulungsprogramme zur gezielten Wissensvermittlung an Ihre Teams.
Warum eine Zusammenarbeit mit Eurofins?
Globale Expertise
Nutzen Sie unser weltweites Netzwerk an BeraterInnen, um die Einhaltung vielfältiger internationaler Vorschriften sicherzustellen – darunter GMP ISO 22716 und DSGVO-Standards.
Maßgeschneiderte Lösungen
Erhalten Sie individuell abgestimmte Audits, Beratungen und Schulungsprogramme, die speziell auf Ihre betrieblichen Anforderungen und Marktziele zugeschnitten sind.
Bewährte Erfolgsbilanz
Mit jahrzehntelanger Erfahrung in der Kosmetik-branche bietet Eurofins C&PC verlässliche Lösungen zur Verbesserung der Produktqualität und zur Beschleunigung des Marktzugangs.
Effiziente Implementierung
Optimieren Sie Ihre Lieferkette und Fertigungsprozesse durch umsetzbare Erkenntnissen, die die Einhaltung gesetzlicher Vorgaben berücksichtigen und gleichzeitig höchste Sicherheitsstandards gewährleisten.

Weitere Services
Warum Eurofins als Partner für Audits, Beratung und Schulung?
Eurofins Cosmetics & Personal Care (P&PC) bietet branchenführende Expertise in den Bereichen Auditierung, Beratung und Schulung, um Ihnen bei der Gewährleistung der regulatorischen Konformität auf globalen Märkten zur Seite zu stehen. Von GMP-Audits bis hin zu maßgeschneiderten Schulungsprogrammen unterstützen wir Produktmarken bei der Prozessoptimierung unter gleichzeitiger Einhaltung höchster Sicherheitsstandards.
Mit uns als Partner erreichen Sie einen zeitnahen Marktzugang und verbessern nachhaltig die Produktqualität.
Für weitere Informationen bezüglich GMP-Audits, Beratung und Schulung im Kosmetikbereich besuchen Sie die Eurofins Assurance Website.